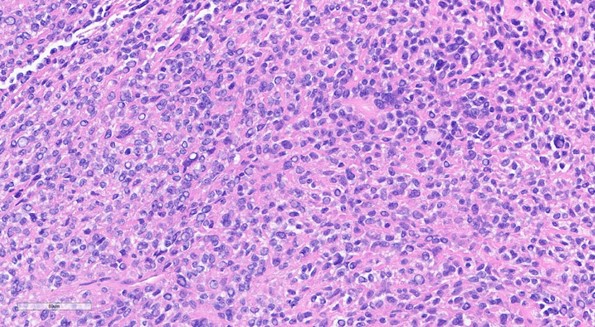

|
Case of the Month: February 2026 Title: 66-year-old female with left frontal lobe tumor Author: Purvi Patel, MD PhD Clinical History: 66-year-old female with presents with seizures and progressive enlargement of anterior cranial fossa presumed meningioma with increased surrounding vasogenic edema approximately 4 years after Gamma Knife surgery. Radiology: Extra axial lesion along the anterior inferior left frontal convexity, demonstrates some mild intrinsic T1 and T2 hyperintense signal, mostly T2/FLAIR hypointense with prominent susceptibility artifact. Moderate amount of T2/FLAIR hyperintense signal within the white matter of anterior and inferior left frontal lobe. Representative Histology / IHC:
Questions for Viewers: 1) What is the differential diagnosis for this lesion? 2) What immunohistochemical stains would help with the differential diagnosis? 3) What are likely molecular alterations found in this lesion? |